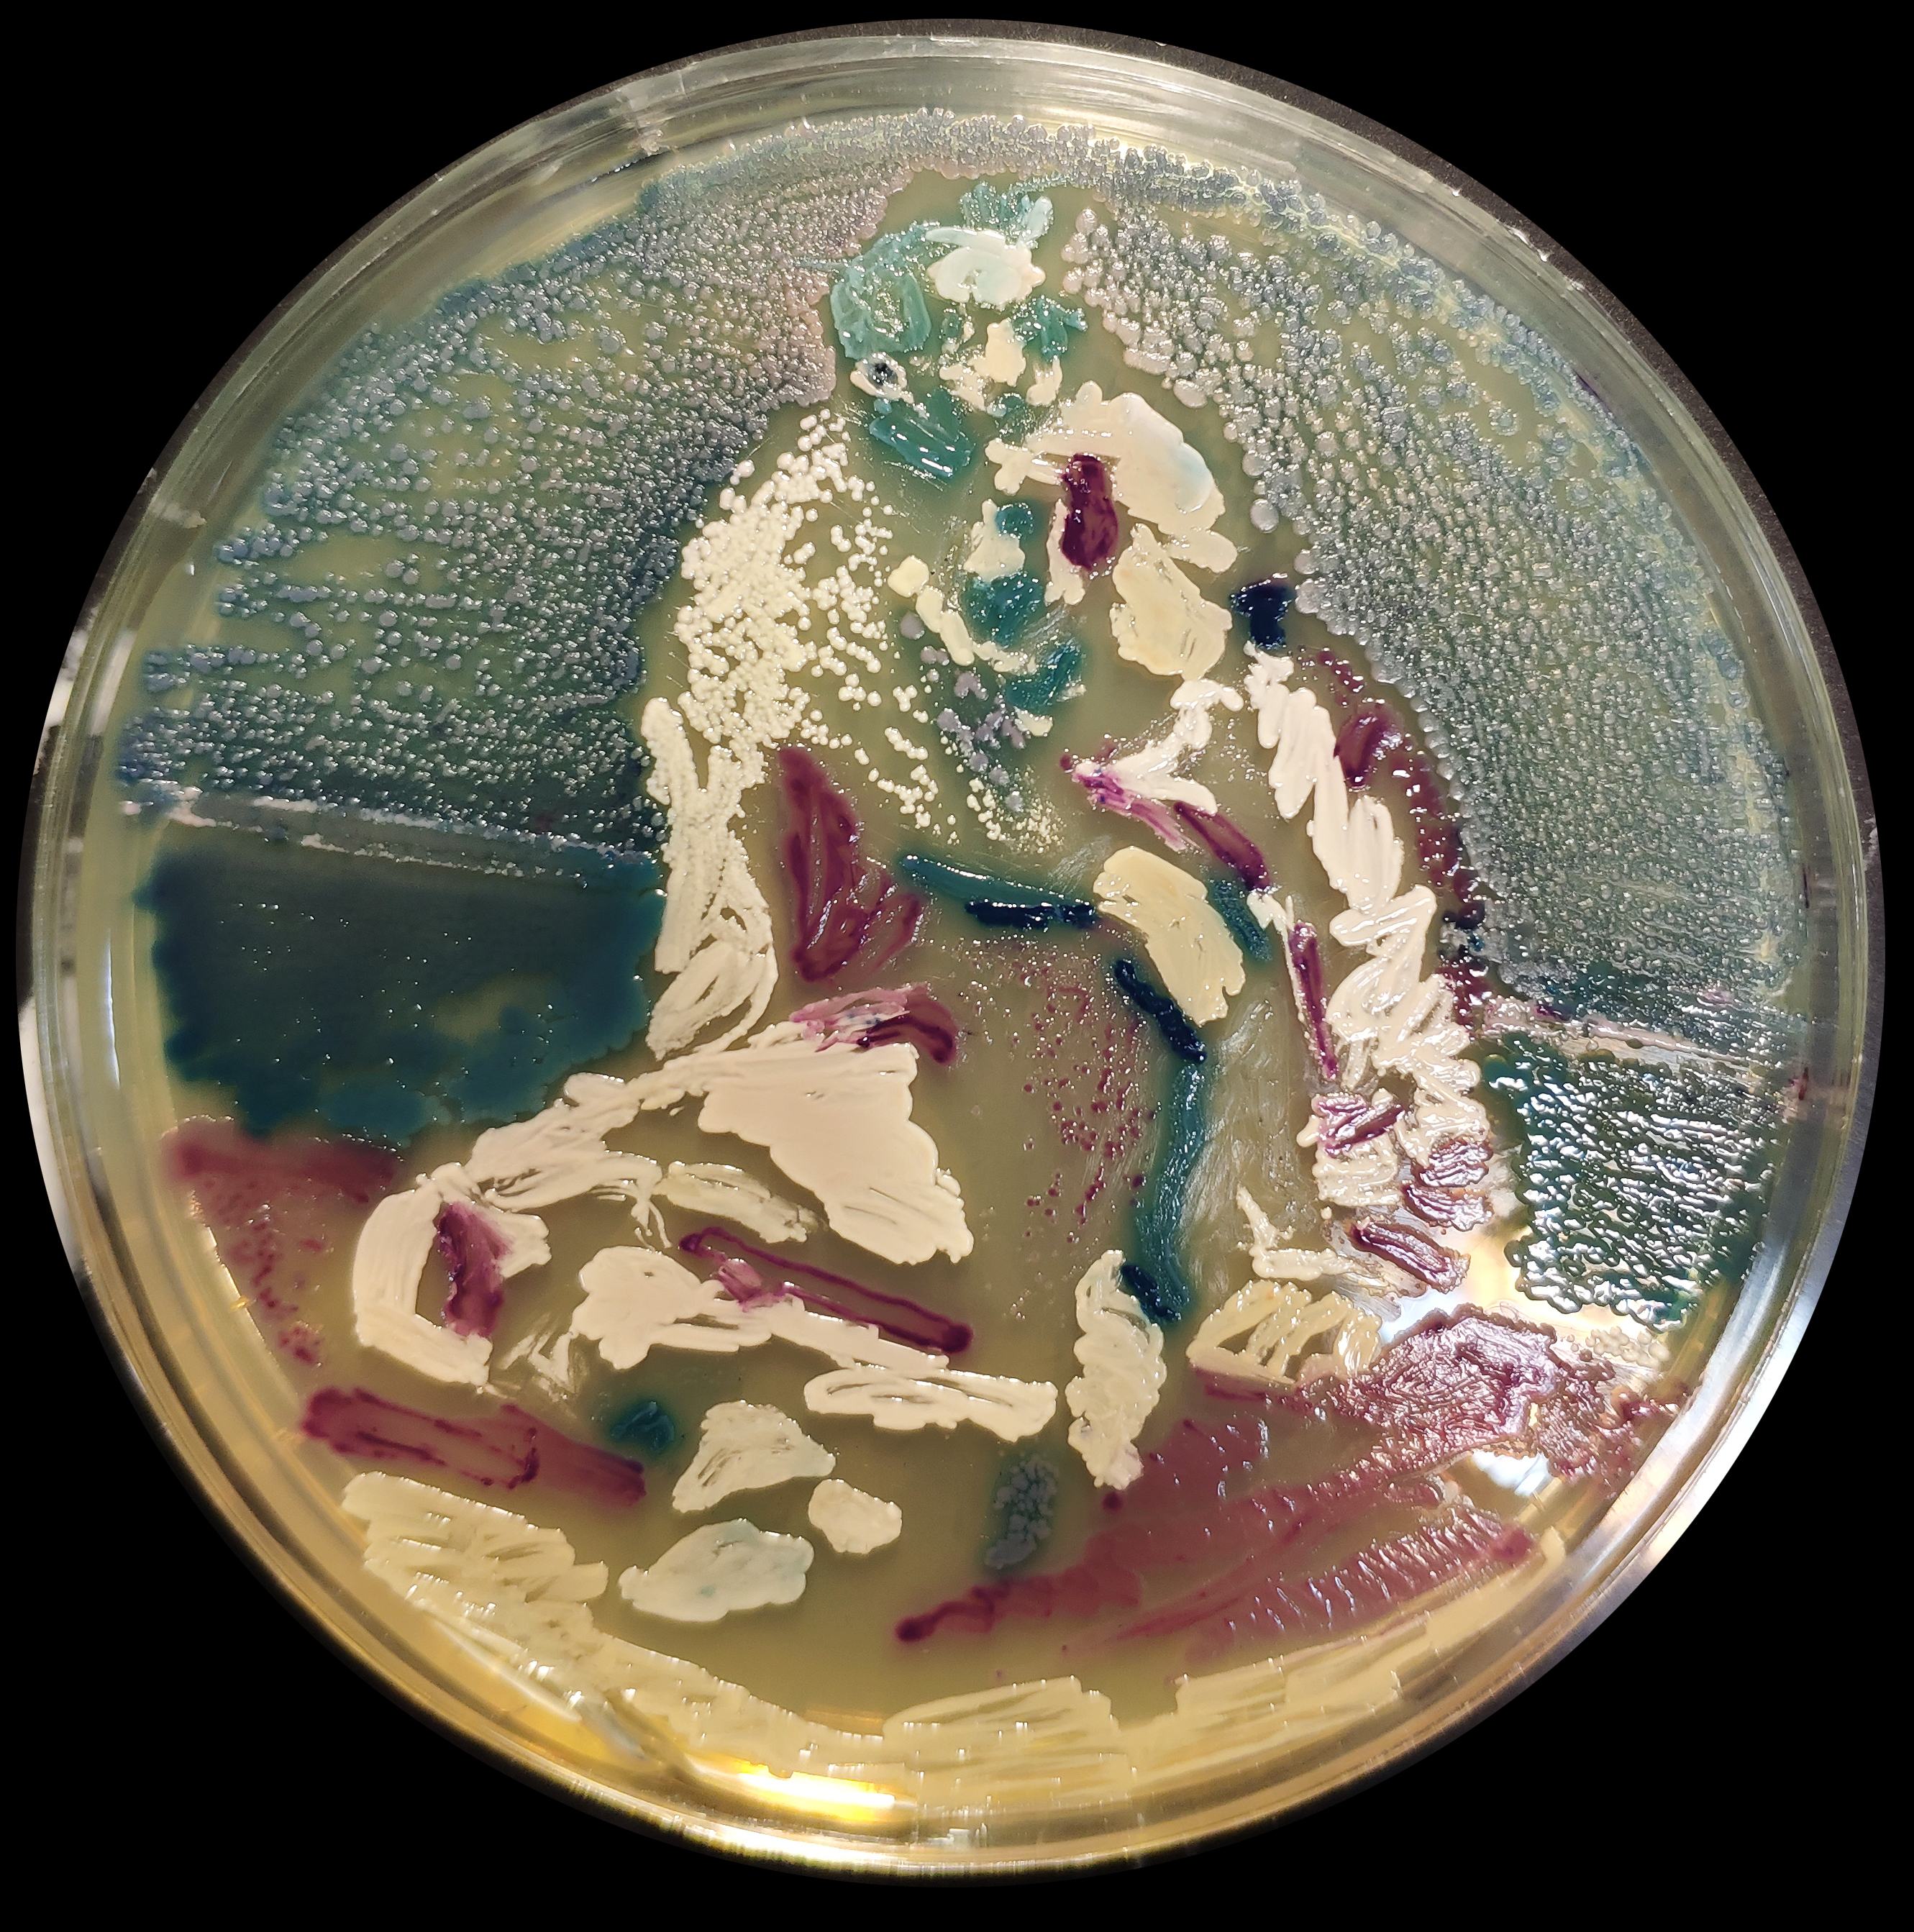

Total ETH Value
0.0013007736 
Global Rank
#9,999,999
User Percentile
%
Total Like
0
Profile Information
Interdisciplinary Artist,
Biological Art, Painting with Bacteria ðŸ¦
Digital Art 👾
M.A in Painting
1/1
This site has been specially prepared for the "Behnamfarahani" user, and "Behnam Farahani" can make any changes to this site if he wishes. In order to access the site content, you need to log in with the metamask wallet.
When you log in, the site will automatically recognize you and you will be able to change your own page.
Anyone who donates to our wallet number at the bottom of the page will automatically gain VIP user status, regardless of small or large size, and will be able to benefit from all services on the site free of charge for life. Thank you for supporting us in this matter.
Rare 3d Metaverse Project
Price
0,3 ♦
Tag
bioart
Collection
bioart

Christmas Day
Painting with Bacteria and Yeast on Agar in 12 Cm Petri Dish. This style of art is unique because after a short time microorganisms will continue to grow a
Price
0 ♦
Tag
bioart
Collection
bioart
Ivan the Terrible and His Son Ivan
Recreating the painting of Ilya Repin with different types of microorganisms. Painting with Bacteria and Yeast on Agar in 15 Cm Petri Dish. This style of
Price
0 ♦
Tag
architectural photography
Collection
signlife

Mailbox
A Old Mailbox in the village in the district of Farahan, Iran.
Price
0,1 ♦
Tag
aerial photography
Collection
signlife

Mom Mirror
An abandoned home in district of Farahan, Iran. The history of the house goes back to about 150 years ago.
Price
0,15 ♦
Tag
abandoned
Collection
signlife

Nobody's Home
An abandoned home in district of Farahan, Iran. The history of the house goes back to about 150 years ago.
Price
0,05 ♦
Tag
painting
Collection
pleasure-320f

Rage
When She Gets Angry No One Can't Stop Her ...